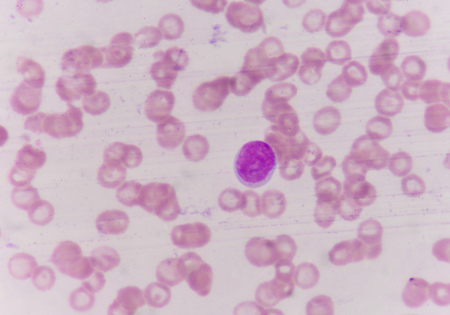
Blast cells in blood smear specimen Leukemia petient.の写真素材

写真素材 - Blast cells in blood smear specimen Leukemia petient.
キーワード
- Microcyte
- abnormal
- acute
- background
- basophil
- blast
- blood
- bone
- cancer
- cell
- cells
- cytoplasm
- decrease
- eosinophil
- granulation
- hematology
- immune
- increase
- infection
- laboratory
- leukemia
- leukocyte
- lymphocyte
- macrocyte
- marrow
- medical
- medicine
- microbiology
- microscope
- monocyte
- neutrophil
- pathology
- phagocytes
- platelet
- red
- response
- slide
- smear
- thalassemia
- toxic
- white
類似作品
Anatomy and His...
Eggs of tapewor...
Eggs of a Taeni...
Drops of blood ...
Fingerprint
watercolor drop...
pink ink drops ...
Purple Ink Spre...
Red blood cells...
Neutrophils are...
Bath bomb disso...
Chronic myeloid...
Fluid Art- liqu...
Defocused chris...
bacteria colony...
Abstract liquid...
Red bubbles in ...
Handmade mucus ...
Fruits of raspb...
red drops of hu...
blood films for...
Acute promyeloc...
CLOSEUP PHOTO O...
Leukemia cells
Red background ...
Detail of blood...
Abstract purple...
Acute promyeloc...
Blast cells in ...
Wine splatter o...
Abstract red wa...
isolated red dr...
Abstract waterc...
Background with...
Chronic myeloid...
Leukemia cells ...
blood in basin,...
Watercolor spla...
Oil bubbles ins...
Paper texture. ...
Splattered bloo...
Epithelial cell...
Eggs of a Taeni...
Eggs of a Taeni...
abstract backgr...
Defocused glitt...
Kitchen sink wi...
Meiosis In Gras...
Abstract liquid...